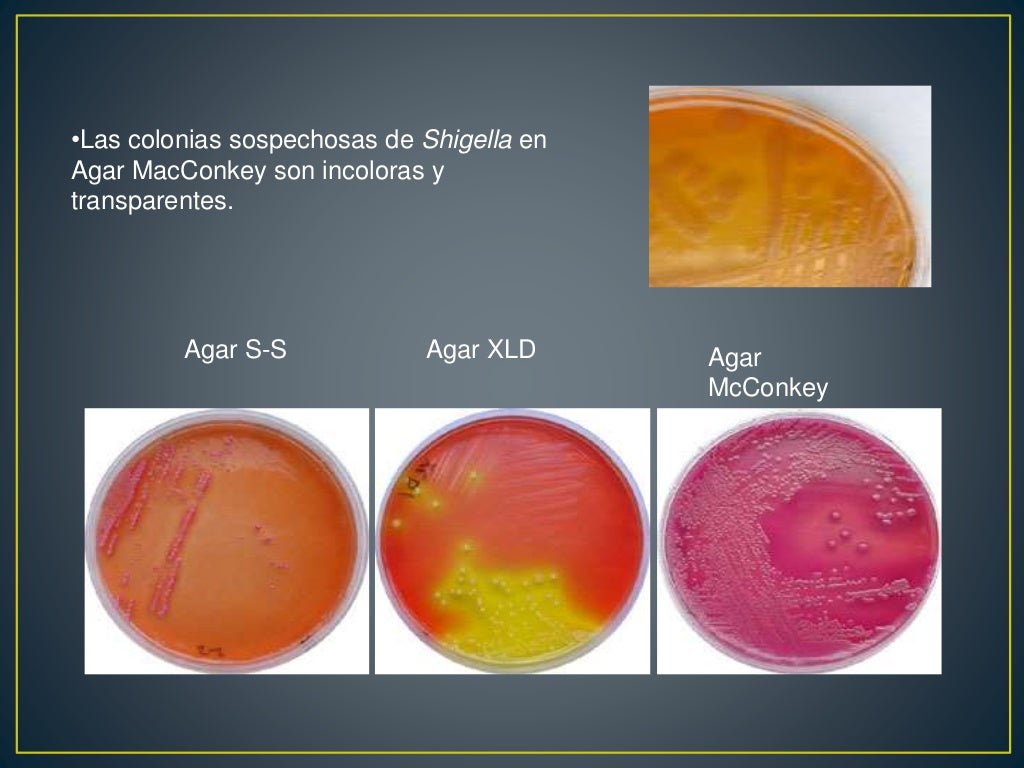

Likewise, xylose-lysine-deoxycholate agar, similar to the differentiating MacConkey and eosine-methylene blue agars, was less inhibitory for defined 'sensitive. 1 2 The agar was developed by Welton Taylor in 1965. Xylose-lysine-deoxycholate and deoxycholate-citrate plates were more effective in recovering enteroinvasive Escherichia coli from faecal samples than was salmonella-shigella agar. Xylose lysine deoxycholate (XLD) agar has been introduced for the isolation of salmonellae and shigellae.
They cause an infectious disease called Shigellosis. Xylose Lysine Deoxycholate agar ( XLD agar) is a selective growth medium used in the isolation of Salmonella and Shigella species from clinical samples and from food. They are non-motile, non-encapsulated, non-sporing, and non-acid-fast bacteria belonging to the family Enterobacteriaceae. MacConkey agar - Wikipedia Xylose Lysine Deoxycholate agar (XLD agar) is a selective growth medium used in the isolation of Salmonella and Shigella species.

The selective agent in XLD Agar is sodium deoxycholate, which inhibits the growth of gram-positive organisms. It has also been found to be an excellent medium for isolating Salmonella species as well. Introduction of Shigella flexneri Shigella are Gram-negative bacilli measuring about 1-3 µm X 0.5 µm. (5) XLD Agar was especially designed to allow the growth of Shigella species, and is a proven medium for the isolation of this organism. DD012 Hektoen Enteric Agar/XLD Agar - DD017 SS Agar/XLD Agar. Read more Categories All Notes, Bacteriology, Basic Microbiology, Immunology/Serology, Miscellaneous Tags and Biochemical reactions in TSI, and Keynotes, and Shigella boydii, and urea agar, B and C2 for Shigella dysenteriae, Bacillary dysentery stool findings, Bacteria, Citrate, Further Readings on Shigella Serotyping, GNB, GNR, Introduction of Shigella Serotyping, Keynotes on Shigella Serotyping, Medicallabnotes, Medlabsolutions, Medlabsolutions9, Microhub, mruniversei, Principle, Principle of Shigella Serotyping, Result and Interpretation of Shigella Serotyping, Result-Interpretation, Salmonella Typhi (black colony) and Shigella boydii growth on XLD agar, Serotyping, Shigella, Shigella flexneri, Shigella flexneri colony morphology on Salmonella-Shigella agar, Shigella polyvalent A, Shigella serotype-Positive, Shigella Serotyping, Shigella Serotyping: Introduction, SIM, Slide agglutination of heat-treated organisms, Test Procedure, Test Procedure of Shigella Serotyping, Test Requirements, Test Requirements for Shigella Serotyping, Universe84a, XLD agar For example, Shigella flexneri serotype 1, 2, 2a, S. More specifically, each serotype has the same number of antigens on its surfaces. Introduction of Shigella Serotyping Shigella Serotyping helps to differentiate serotypes of Shigella. Serotypes refer to separate groups within a species of microorganisms that all share a similar property.
